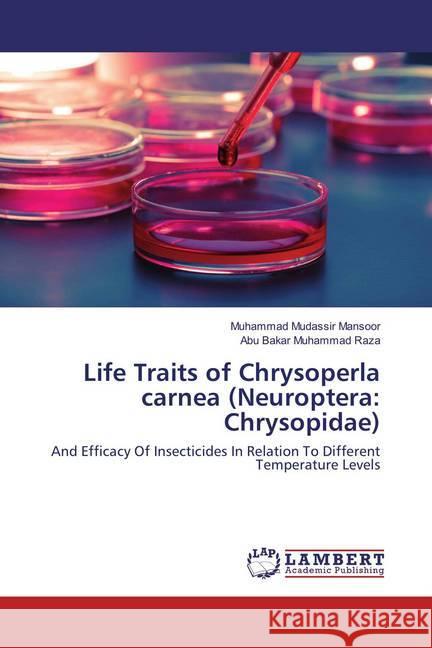
Life Traits of Chrysoperla carnea (Neuroptera: Chrysopidae) : And Efficacy Of Insecticides In Relation To Different Temperature Levels Mansoor, Muhammad Mudassir; Muhammad Raza, Abu Bakar 9783659855832 LAP Lambert Academic Publishing - książka

Life Traits of Chrysoperla carnea (Neuroptera: Chrysopidae) : And Efficacy Of Insecticides In Relation To Different Temperature Levels » książka
Life Traits of Chrysoperla carnea (Neuroptera: Chrysopidae) : And Efficacy Of Insecticides In Relation To Different Temperature Levels
ISBN-13: 9783659855832 / Angielski / Miękka / 2016 / 88 str.
Life Traits of Chrysoperla carnea (Neuroptera: Chrysopidae) : And Efficacy Of Insecticides In Relation To Different Temperature Levels
ISBN-13: 9783659855832 / Angielski / Miękka / 2016 / 88 str.
(netto: 236,62 VAT: 5%)
Najniższa cena z 30 dni: 245,00
ok. 10-14 dni roboczych.
Darmowa dostawa!
The common green lacewing Chrysoperla carnea is a key biological control agent employed in integrated pest management (IPM) programs for managing various insect pests. The use of insecticide-resistant natural enemies can prevent secondary pest outbreaks and pest resurgence in many cropping systems in which chemical management of pests is a common practice. In the field, temperature has a prominent effect on insecticide effectiveness. It is a key factor of the environment which acts as a controlling and lethal factor. Temperature coefficient of any insecticide may be calculated to find the temperature-toxicity association. Insecticides with a positive temperature coefficient become more toxic with the increase in temperature, whereas, those with a negative temperature coefficient become more toxic at lower temperatures.